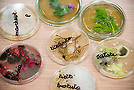

Aktualności
Noc Biologów za nami
15-01-2018
Noc Biologów, największe wydarzenie cykliczne popularyzujące nauki przyrodnicze, organizowane jest przez szkoły wyższe i ośrodki naukowe w całej Polsce od 2012 roku. W tej edycji po raz pierwszy udział wzięła Państwowa Wyższa Szkoła Zawodowa w Krośnie, jako jeden spośród 32 ośrodków w Polsce, a zarazem druga uczelnia w województwie podkarpackim.
Oficjalnego otwarcia pierwszej krośnieńskiej Nocy Biologów dokonał Bronisław Baran, Zastępca Prezydenta Miasta Krosna, zaś ze strony uczelni gości powitał Franciszek Tereszkiewicz, Kanclerz PWSZ w Krośnie. Koordynatorem wydarzenia była dr Renata Rabiasz, dyrektor Instytutu Zdrowia i Gospodarki PWSZ w Krośnie.
Udział w organizowanym wydarzeniu zgłosiło ponad 200 osób, głównie byli to uczniowie szkół ponadgimnazjalnych z Krosna i okolic, nie zabrakło również osób dorosłych i dzieci. Dla przybyłych gości zaplanowano serię wykładów i warsztatów, przygotowano również stoiska konkursowe i wystawy. Uczestnicy Nocy Biologów mogli dowiedzieć się jak powstało życie na ziemi od bakterii do organizmów złożonych, jak postępowała roślinna kolonizacja lądu, czy też ocenić ile cukru jest w cukrze oraz w jaki sposób można oznaczyć witaminę C w surowcach roślinnych.
Oferta przygotowana przez pracowników Instytutu Zdrowia i Gospodarki pozwoliła każdemu z miłośników nauk przyrodniczych wybrać tematykę zajęć zgodną z zainteresowaniami.
Ze względu na duże zainteresowanie wydarzeniem, krośnieńską Noc Biologów z pewnością warto będzie powtórzyć w kolejnych latach.
Więcej informacji na głównej stronie Uczelni
http://archiwum.pwsz.krosno.pl/galeria-zdjec/galeria,408.html

Zakupu oprogramowania dokonano w ramach projektu “Budowa szerokopasmowej regionalnej sieci internetowej w Krośnie i w powiecie krośnieńskim współfinansowanego przez Unię Europejską z Europejskiego Funduszu Rozwoju Regionalnego w ramach Zintegrowanego Programu Operacyjnego Rozwoju Regionalnego"